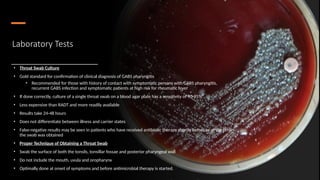
Laboratory Tests
• Throat Swab Culture
• Gold standard for confirmation of clinical diagnosis of GABS pharyngitis
• Recommended for those with history of contact with symptomatic persons with GABS pharyngitis,
recurrent GABS infection and symptomatic patients at high risk for rheumatic fever
• If done correctly, culture of a single throat swab on a blood agar plate has a sensitivity of 90-95%
• Less expensive than RADT and more readily available
• Results take 24-48 hours
• Does not differentiate between illness and carrier states
• False-negative results may be seen in patients who have received antibiotic therapy shortly before or at the time
the swab was obtained
• Proper Technique of Obtaining a Throat Swab
• Swab the surface of both the tonsils, tonsillar fossae and posterior pharyngeal wall
• Do not include the mouth, uvula and oropharynx
• Optimally done at onset of symptoms and before antimicrobial therapy is started.

Tonsillopharyngitis, commonly referred to as strep throat, is an acute infection affecting the pharynx and tonsils, primarily caused by viral agents but also including bacterial infections like group A strep. Diagnosis involves clinical evaluation and specific tests such as throat swabs, and treatment includes symptomatic relief and antibiotics when necessary, particularly for bacterial causes. Patient education on hygiene and management of symptoms is crucial for minimizing transmission and improving recovery.


![Etiology
• Viral
• Main cause of acute tonsillopharyngitis
• Double-stranded DNA viruses (human adenovirus,
Epstein-Barr virus), single-stranded RNA viruses
(influenza, para-influenza, rhinovirus, enteroviruses,
Coxsackie virus, coronaviruses, respiratory syncytial virus
[RSV], human meta-pneumo-virus), and retroviruses
(human immunodeficiency virus [HIV]) are among the
viral causes
• Bacterial
• Responsible for about 5-15% of clinic consultations for
acute sore throat in adults
• Most commonly caused by Gram-positive cocci known
as S pyogenes
• This organism exhibits beta-hemolysis on blood
agar plates
• Belongs to group A Lancefield classification system
for beta-hemolytic strep infection
• Other bacterial causes include group C and
G Streptococci, Hemophilus
influenzae, Nocardia, Corynebacteria and Neisseria
gonorrhoeae](https://image.slidesharecdn.com/diagnosticmethodsfortonsillopharyngitis-acute-241221110208-2bc47b6e/85/DIAGNOSTIC-METHODS-FOR-TONSILLOPHARYNGITIS-ACUTE-pptx-3-320.jpg)





![Conditions Where Lab Tests for GABS are Not
Available or Not Practical
Antibiotics will not be needed for every patient that presents with sore throat
Antibiotics should not be withheld if the clinical condition is severe or GABS is suspected
Modified Centor score or FeverPAIN can be used to decide
on which patients need no testing, lab tests (throat swab or
rapid antigen detection test [RADT]) or empiric antibiotic
therapy
Score of 0 to 1 does not require testing or antibiotic therapy
Patients with score of 2 or 3 require testing, positive results warrant
empiric therapy
Score of ≥4 is at high risk of GABS and empiric therapy is considered](https://image.slidesharecdn.com/diagnosticmethodsfortonsillopharyngitis-acute-241221110208-2bc47b6e/85/DIAGNOSTIC-METHODS-FOR-TONSILLOPHARYNGITIS-ACUTE-pptx-9-320.jpg)